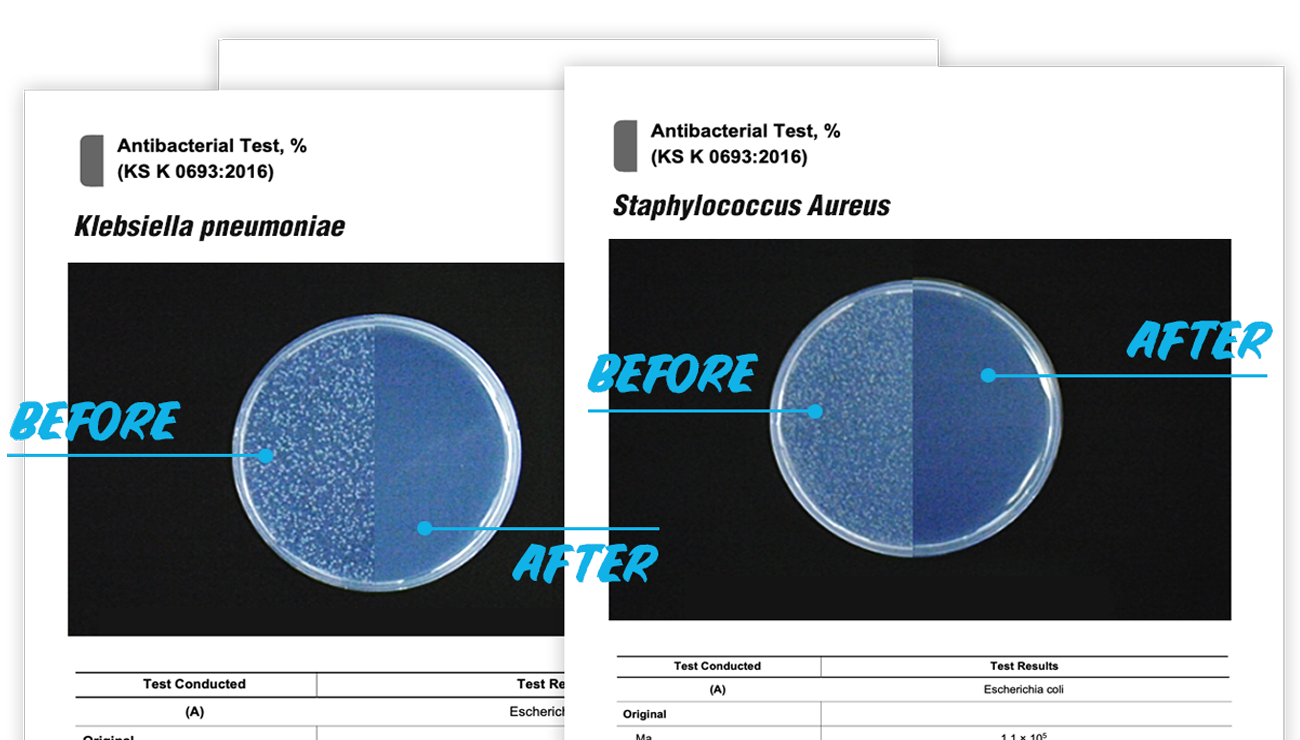

How BeKlyn Works?
-
E.coli
-
Pneumococcus
-
Pyogenic Bacillus
-
Pseudomonas Aeruginosa
Kills 99% Of Bacteria Without Alcohol
BeKLYN Absolute Purifying Sanitizers are powerful disinfectant made to defend against harmful organisms using TiO2 multi-photocatalysis activity.
Kills 99% Of Bacteria On Contact In 15 Seconds.
*when used as directed, Absolute Purifying Sanitizers are effective against bacteria and viruses including Ammonia, Trimethylamin, Acetic acid, E.Coli, Pneumococcus, Pyogenic Bacillus and Pseudomonas Aeruginosa, etc.
How Our Multi-Photocatalysis Technology Works
A quick-acting formula that sterilizes and kills 99.9% of harmful bacteria and viruses within 15 seconds.
Oxygen anions from TiOH react and absorb ambient H2O in the air
Formulation of -OH radicals ('electronholes') are created from Oxygen & H2O reaction
-OH radicals react with pollutants an dsterilizes air tore form non-toxic CO2 + H20
TiOH reacts with new oxygen compoundsto release additional -OH radicals and form TiO2
-OH emissions repeats sterilization efforts to kill bacteria and germs
| BeKlyn™ Titanium Dioxide based Sanitizers |
Alcohol based Sanitizers | Benzalkonium Chloride based Sanitizers | |
|---|---|---|---|
| Kills 99% of bacteria | |||
| Dry Skin and Risk of Infection | |||
| Fire Hazard | |||
| Chemical Toxicity |
Gentle & Safe On Skin.
No parabens, no sulfates, no toxic chemicals. Our formulations are designed with a pH of 5.5-7 so you can protect your home and family without worry.
See Absolute Purifying Hand Gel
Sanitizes Both Hard & Soft Surfaces Against Bacteria.
Use on a variety of hard, non-food-contact and soft surfaces, including washable fabric, plastic, upholstery, painted wood, painted surfaces, vinyl, stainless steel, aluminum, glazed ceramic, sealed granite and marble.
See Absolute Purifying Sanitizing Spray
